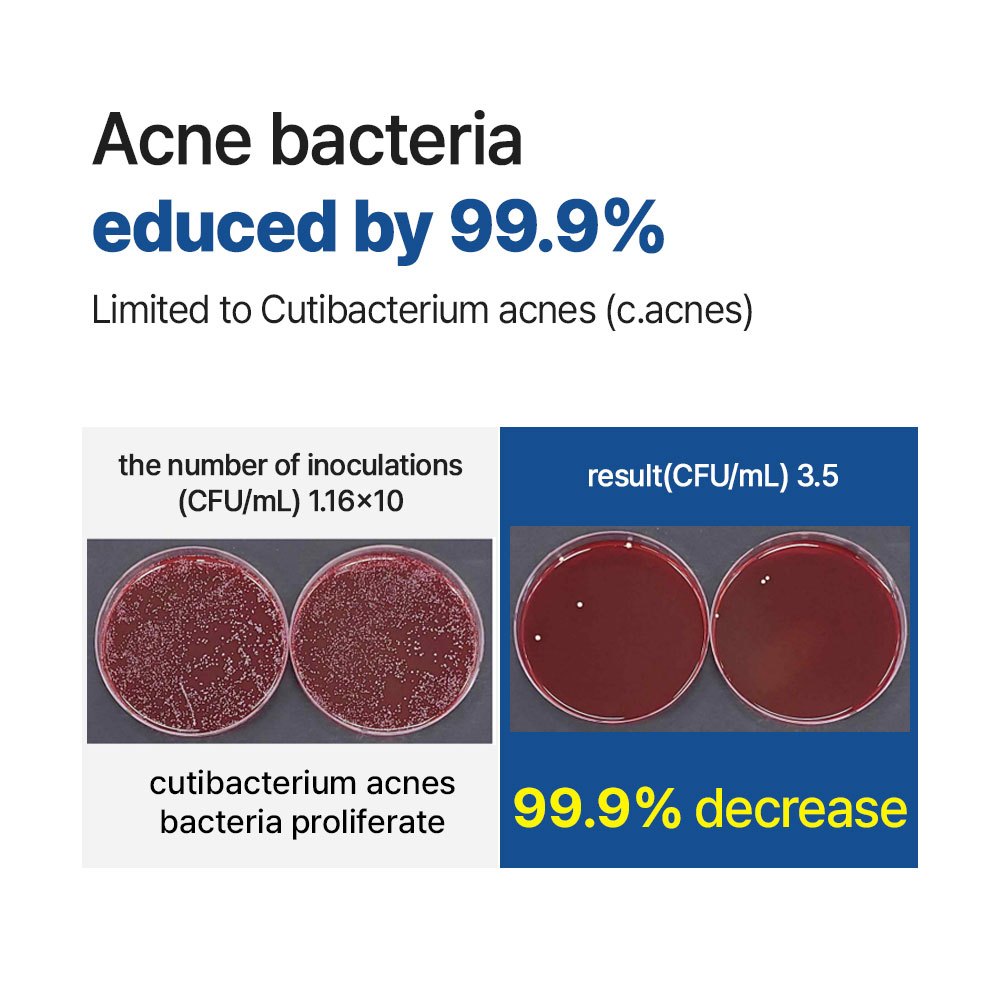

1/9
no Pix >
Gustus acne Lavagem Corporal Antibacteriana Higiênica Masculina Coreana Sabonete Para Pele Sensível gel De Banho
Frete grátis R$13,00 R$0,00 com cupom
Produto internacional objeto de declaração de importação e sujeito a impostos estaduais e federais